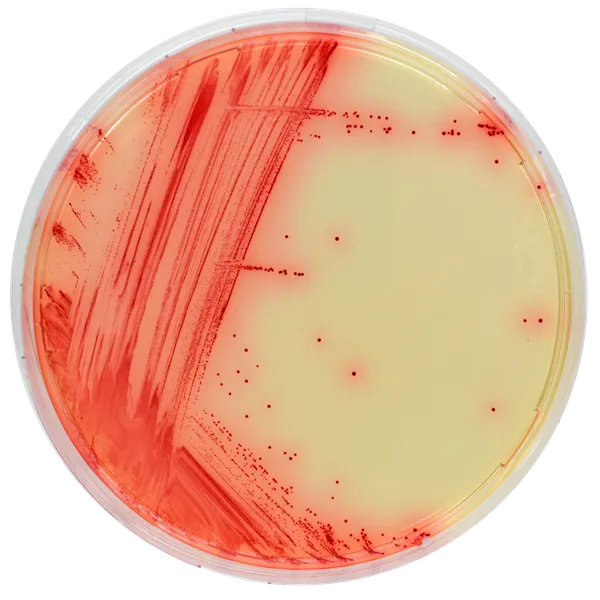
CHROMagar™ Mycoplasma
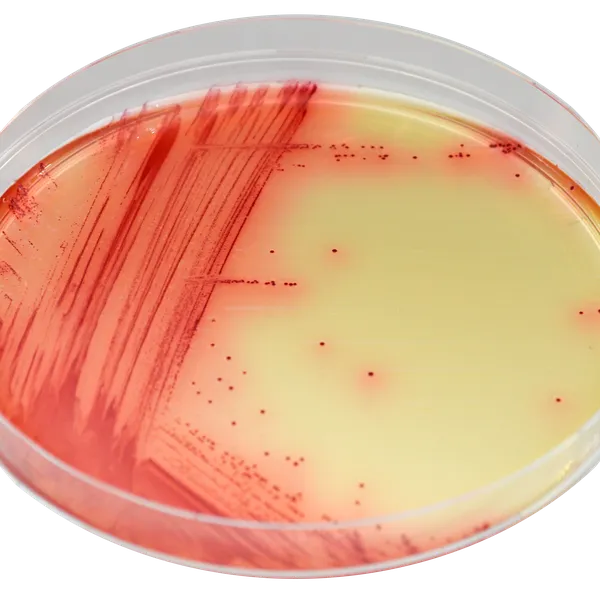
CHROMagar™ Mycoplasma

Hình thái khuẩn lạc

Mycoplasma bovis
Màu đỏ

Mycoplasma bovis
dưới kính lúp
Hiệu năng
Hiệu năng
Ứng dụng
Các bệnh nhiễm khuẩn ở bò có thể dẫn đến nhiều dấu hiệu lâm sàng, như viêm phổi chủ yếu nhưng cũng có thể viêm khớp, viêm vú và viêm kết mạc, không triệu chứng nào là đặc trưng cho M. bovis. Do đó, chẩn đoán phòng thí nghiệm là rất quan trọng.
Việc nhận diện M. bovis từ mẫu gạc mũi, dịch rửa phế quản phế nang có thể thực hiện bằng cách cấy mẫu trực tiếp lên đĩa thạch CHROMagar™ Mycoplasma.
Việc phát hiện M. bovis nhờ vào màu đỏ cho phép nhận diện dễ dàng với hình thái trứng ốp la dưới kính lúp sau 3-7 ngày nuôi cấy ở 37 °C trong môi trường CO2.
1. DỄ ĐỌC VÀ GIẢI THÍCH
Với CHROMagar™ Mycoplasma, khuẩn lạc có màu đỏ đậm và hình thái trứng ốp la - giúp việc phát hiện trở nên rất dễ dàng.
2. PHÁT HIỆN
Phát hiện có thể thực hiện trong vòng 3 đến 7 ngày trong môi trường CO2 .
3. PHƯƠNG PHÁP ĐƠN GIẢN
Nhận diện M. bovis từ mẫu gạc mũi và dịch rửa phế quản phế nang có thể thực hiện bằng cách cấy trực tiếp mẫu lên đĩa.
Thành phần

Tài liệu kỹ thuật
Công bố khoa học
2023
Performance of CHROMagar™ Mycoplasma - Chromogenic Culture Medium for Detection of Mycoplasma bovis.
? Publication

Xem thêm